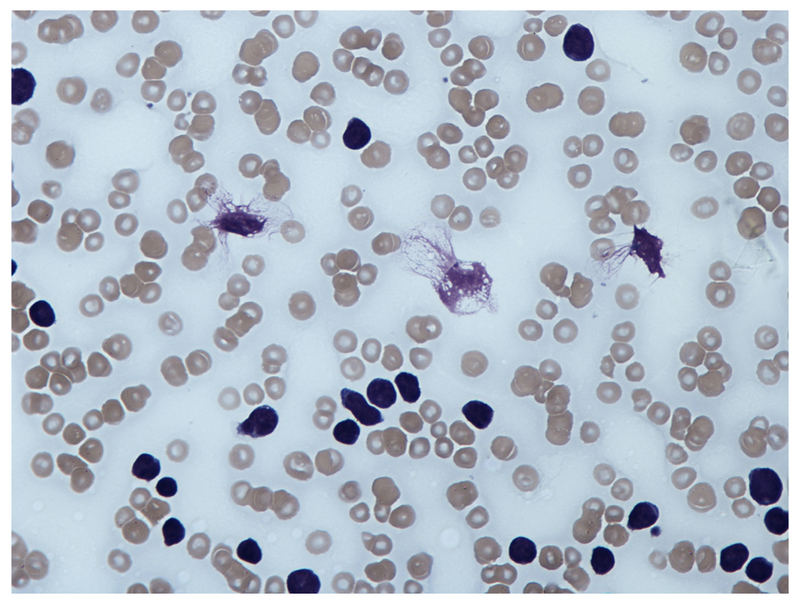

CLL is considered a lymphoproliferate disorder of [ cell type ], which results from an abnormal clonal expansion of [ cell type ] that resemble mature [ cell type ]
CLL is considered a lymphoproliferate disorder of B lymphocytes, which results from an abnormal clonal expansion of B cells that resemble mature lymphocytes.
What are the common genetic alterations seen in CLL?
- most common genetic change is the deletion in chromosome 13
- TP53 mutation
- Trisomy 12: presence of an extra 12th chromosome
- Overexpression of BCL2 proto-oncogene: suppresses programmed cell death (i.e. increases cell survival)
What is meant by Richter’s transformation? [1]
CLL can evolve into B-cell pro-lymphocytic leukaemia and transform to a higher grade non-Hodgkin lymphoma.
About 2 to 10% of CLL cases develop into diffuse large B-cell lymphoma (called Richter’s transformation).
Describe the natural history of CLL
- An initial inciting event or abnormal reaction to an antigen stimulus leads to genetic alterations that allow the formation of a clone of B lymphocytes
- This is a premalignant disorder, which is referred to as monoclonal B cell lymphocytosis (MBL).
- Overtime, further genetic mutations and bone marrow microenvironment changes promote the progression to CLL. This transformation from MBL to CLL occurs at a rate of 1% per year.
- A proportion of patients who develop CLL may remain asymptomatic for many years. However, others may get rapidly progressive disease with complications associated with the defective immune function including cytopaenias and hypogammaglobulinaemia (i.e. low antibody levels).
The symptomatic stage of CLL is characterised by progressive lymphadenopathy, which includes splenomegaly and hepatomegaly, that occurs due to the accumulation of incompetent lymphocytes.
The hallmark feature of CLL is [] due to the infiltration of []
The hallmark feature of CLL is lymphadenopathy due to the infiltration of malignant B lymphocytes.
- symmetrically enlarged lymph nodes in the neck, armpits or groin which is seen in more than 80% of patients at the time of diagnosis
What would indicate that CLL may be active in a patient? [3]
The onset of the classic “B symptoms” is a sign that the CLL may be active. The symptoms include:
* Frequent, severe night sweats
* Unexplained weight loss >10% of body weight in the previous 6 months
* High fever in the absence of any infections (>38°C)
What are the features associated with complications of CLL?
Autoimmune haemolytic anaemia: pallor, dyspnoea, weakness, dizziness
Immune thrombocytopaenia: petechiae, bruising, mucosal bleeding
Hypogammaglobulinaemia: recurrent infections (organ specific)
Describe how you would investigate for CLL [4]
FBC:
- Presence of excess lymphocytes on full blood count that are found to be clonal
PBS:
- indicated to confirm lymphocytosis
- presence of smudge cells artefacts from lymphocytes damaged during the slide preparation because of the fragile nature of these cells.
Immunophenotyping:
- shows the characteristic clonal B lymphocytes expressing CD5 and CD23 antigens.
- detect deletion of TP53 gene
Why might you perfom a Direct antiglobulin test (coombs test) with a query CLL patient? [1]
It should be done in all anaemic patients and before commencing therapy to identify autoimmune-related haemolytic anaemias.
Describe the staging criteria for CLL (there are two)
Binet staging - used more in the UK
* Stage A: < 3 lymphoid sites
* Stage B: ≥ 3 lymphoid sites
* Stage C: presence of anaemia ( < 100 g/L) and/or thrombocytopaenia (< 100 x10^9/L)
Rai staging
* Stage 0 (lymphocytosis): 25% at initial diagnosis
* Stage I-II (lymphocytosis + lymphadenopathy + organomegaly): 50% at initial diagnosis
* Stage III-IV (lymphocytosis + anaemia or thrombocytopaenia +/- lymphadenopathy/ organomegaly): 25% at initial diagnosis
State indications for iniating treatment of CLL [7]
- Bone marrow failure (Hb < 100 g/L, plts < 100 x10^9/L)
- Massive, progressive or symptomatic splenomegaly (≥6 cm below costal margin)
- Massive, progressive or symptomatic lymphadenopathy (≥10 cm)
- Progressive lymphocytosis (≥50% over 2 months or doubling time < 6 months)
- Autoimmune complications not responsive to steroids (e.g. ITP/AIHA)
- Symptomatic/functional extranodal sites (e.g. skin, kidney, lung, spine)
- Disease-related symptoms (e.g. significant weight loss, severe fatigue, >2 weeks of fever or ≥1 month of night sweats without infection)
Describe the treatment plan for CLL
The standard treatment of patients with the early disease is a watch and wait strategy
Patients with active, symptomatic disease: chemotherapy
Describe the treatment options for those with active CLL [+]
Chemotherapy
* Chlorambucil: cross-links DNA leading to damage and apoptosis. Given orally.
* Fludarabine: purine analog that inhibits DNA synthesis. Given orally or intravenously.
* Bendamustine: alkylating agent that cross-links DNA causing damage.
Small molecule inhibitors
* Ibrutinib: tyrosine kinase inhibitor. Usually reserved for CLL with TP53 mutations
* Idelalisib: phosphoinositide 3-kinase inhibitor. Often used in combination with rituximab in relapsed/refractory disease.
* Venetoclax: BCL2 inhibitor. May be used in relapsed/refractory disease.
Monoclonal antibodies
* Rituximab/Obinutuzumab/Ofatumumab: Anti-CD20 antibodies that target B lymphocytes (i.e. lymphocyte depleting agent)
Other
* Corticosteroids: may be used as a single agent in extremely frail patients. May be prescribed to treat autoimmune complications including haemolytic anaemia and immune thrombocytopaenia.
What does NICE recomennd for CLL patients who are previously untreated and without TP53 mutations [3]
Fludarabine, cyclophosphamide and rituximab (FCR)
What is the treatment advised by NICE for the first-line treatment of CLL (Binet stage B or C) in patients for whom FCR chemotherapy is not appropriate? [1]
Chemotherapy with bendamustine is advised by NICE as an option for the first-line treatment of CLL (Binet stage B or C) in patients for whom FCR chemotherapy is not appropriate.
For patients with FCR or bendamustine-based therapy unsuitable, what treatment does NICE recommend? [2]
For adults with FCR or bendamustine-based therapy unsuitable, NICE recommends obinutuzumab in combination with chlorambucil as an option.
What is the treatment NICE rec. for patients with TP53 deletion/mutation have a poor prognosis even after first line FCR combined chemotherapy? [1]
Patients with TP53 deletion/mutation have a poor prognosis even after first line FCR combined chemotherapy. In such cases, chemo agents like ibrutinib can be used.
[] is a monoclonal antibody which has also been shown to be effective in TP53 mutations.
Alemtuzumab is a monoclonal antibody which has also been shown to be effective in TP53 mutations.
[] is the dominant clinical feature among the complication in CLL, which should be treated with [].
Auto‐immune cytopenia is the dominant clinical feature among the complication in CLL, which should be treated with corticosteroids.
[] provides the best opportunity of achieving long‐term disease‐free survival for patients with high‐risk CLL, including those with TP53 abnormalities.
Allogeneic stem‐cell transplantation provides the best opportunity of achieving long‐term disease‐free survival for patients with high‐risk CLL, including those with TP53 abnormalities.
It is a potential option in patients who fail chemotherapy and BCR inhibitor therapy or those with TP53 mutations that do not respond to treatment or relapse. In addition, it can also be considered in those with Richter transformation
Describe potential prophylaxis treatment might give patients with CLL? [4]
Vaccination: influenza, pneumococcal (ensure no contraindication with current therapy)
Antibiotics for infections
Consider intravenous immunoglobulin: treatment of secondary hypogammaglobulinaemia (i.e. IgG < 5g/L)
Consider Pneumocystis jirovecii pneumonia (PJP) and herpes zoster prophylaxis: usually in patients on treatment for relapsed CLL
Which chromosome deletion in CLL has bad prognostics? [1]
Chromosome 17 deletion
Describe the treatment plan for CLL
- Watch and wait (and vaccinate), until have symptoms or cytopaenias - unless otherwise the CLL is not introducing harm, and giving treatment might cause resistance or harm to patient
- Small molecules: Ibrutinib; Immunotherapy
Lectures


